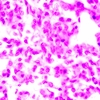
image preview

Микроскоп биологический MAGUS Bio 270T
Микроскоп биологический MAGUS Bio 270T.
Увеличение: 40–1000 крат. Тринокулярная визуальная насадка, кодированный револьвер, объективы-планахроматы, светодиодный осветитель 3 Вт, интеллектуальная система управления освещением.
Микроскоп исследовательского класса. Предназначен для наблюдения прозрачных и полупрозрачных биологических образцов в виде мазков и срезов в проходящем свете в светлом поле. Установка опциональных компонентов позволит использовать методы темного поля, фазового контраста, люминесценции и поляризации.
Кодированный револьвер сохраняет комфортную яркость при переключении объективов. Интеллектуальное управление освещением микроскопа повышают комфорт, скорость и эффективность работы исследователя. Благодаря «умным» функциям не нужно отвлекаться на настройки, внимание исследователя полностью сфокусировано на решаемых задачах.
Основные особенности микроскопа:
- Наблюдения прозрачных и полупрозрачных образцов в светлом поле в проходящем свете
- Тринокулярная насадка с вертикальным тубусом для установки цифровой камеры и изменением высоты для подстройки под рост наблюдателя; деление светового потока 50/50
- Кодированное револьверное устройство – яркость источника света устанавливается автоматически в зависимости от выбранного объектива
- Осветитель проходящего света – экономичный светодиод 3 Вт со сроком службы до 50 000 часов
- Освещение по Кёлеру в проходящем свете, центрируемый и регулируемый по высоте конденсор с маркировкой апертуры объективов
- Интеллектуальная система управления освещением: автоматический выбор яркости, блокировка регулировки яркости, автоотключение по таймеру, ЖК-экран статуса работы
- Предметный столик без выдвижной рейки и с длинной ручкой управления для удобной работы
- Эргономичный штатив с ручкой для переноски и скрытым размещением сетевого шнура и адаптера питания
- Широкая линейка дополнительных аксессуаров
Комплектация:
- Штатив со встроенным источником электропитания, источником проходящего света, механизмом фокусировки, предметным столиком, кронштейном конденсора и револьвером объективов
- Конденсор Аббе
- Тринокулярная визуальная насадка
- Объектив-планахромат, рассчитанный на бесконечность: 4x/0,10, парфокальная высота 60 мм
- Объектив-планахромат, рассчитанный на бесконечность: 10x/0,25, парфокальная высота 60 мм
- Объектив-планахромат, рассчитанный на бесконечность: 40x/0,65, парфокальная высота 60 мм
- Объектив-планахромат, рассчитанный на бесконечность: 100x/1,25 ми (подпружиненный), парфокальная высота 60 мм
- Окуляр 10x/22 мм с удаленным зрачком и диоптрийной коррекцией (2 шт.)
- Наглазник на окуляр (2 шт.)
- Переходник под крепление C-mount для работы с камерой
- Адаптер питания и сетевой шнур питания для микроскопа
- Пылезащитный чехол
- Инструкция по эксплуатации и гарантийный талон
Характеристики:
- Конструкция микроскопа: прямой
- Поле изображения: плоское
- Методы исследования в проходящем свете: светлое поле;
*опционально: темное поле, люминесценция, поляризованный свет, фазовый контраст - Увеличение (базовая комплектация): 40–1000×
*Опционально: до 1250/1500/2000× - Длина тубуса: бесконечность (∞)
- Визуальная насадка: тринокулярная, тип Gemel (Зидентопф с поворотом тубусов на 360°), угол наклона 30°
- Распределение светового потока (окуляры / канал визуализации): фиксированное 50/50
- Собственное увеличение насадки: 1×
- Межзрачковое расстояние: 47–78 мм
- Посадочный диаметр окуляров: 30 мм
- Окуляры (в комплекте): 10×/22 с диоптрийной коррекцией ±5D, удалённый зрачок
*Опции: 10×/22 со шкалой, с сеткой, с перекрестьем; 12,5×/17,5; 15×/16; 20×/12 - Револьверное устройство: на 5 объективов, кодированное
- Тип коррекции объективов: планахроматы, рассчитаны на длину тубуса «бесконечность» (∞), парфокальная высота 60 мм
- Объективы (в комплекте):
- 4×/0,10 / раб. расст. 30 мм
- 10×/0,25 / раб. расст. 10,2 мм
- 40×/0,65 / раб. расст. 1,5 мм
- 100×/1,25 ми / раб. расст. 0,2 мм
- Пружинящая оправа фронтальной линзы: у объектива 100×
- Предметный столик: 235 × 150 мм, двухкоординатный механический, без выдвижной рейки
- Диапазон перемещения препарата: 78 × 54 мм
- Конденсор: центрируемый и регулируемый по высоте конденсор Аббе NA 0,9 с ирисовой апертурной диафрагмой; крепление «ласточкин хвост»
- Полевая диафрагма: регулируемая ирисовая
- Механизм фокусировки: коаксиальные рукоятки грубой и тонкой фокусировки, расположены с двух сторон
- Ход грубой фокусировки: 32 мм (18,85 мм/оборот)
- Ход тонкой фокусировки: 0,1 мм/оборот
- Механизм регулировки жёсткости грубой фокусировки: есть
- Механизм блокировки грубой фокусировки: есть
- Способ освещения: проходящий свет
- Источник света: светодиод 3 Вт с регулировкой цветовой температуры (3000–7000 К)
- Интеллектуальная система управления освещением:
- автоматическая регулировка яркости при смене объектива
- отображение статуса на ЖК-экране
- режим ожидания и эко-режим
- Фазово-контрастное устройство (*опция):
- фазово-контрастный конденсор (вращающийся диск)
- фазовые объективы (10×, 20×, 40×, 100×)
- вспомогательный центрирующий телескоп
- Конденсор темного поля (*опция):
- сухой — NA 0,7–0,9 (для сухих объективов)
- масляный — NA 1,3–1,26 (для иммерсионного объектива 100×)
- Устройство для люминесценции (*опция): люминесцентная насадка
- Устройство простой поляризации (*опция):
- поляризатор — устанавливается на коллектор
- анализатор — устанавливается в слот штатива над револьвером
- Источник питания: сеть переменного тока 100–240 В / 50–60 Гц;
внешний адаптер AC/DC крепится в специальном гнезде на задней части штатива - Рабочая температура: 5–30 °C
- Рабочая влажность: 0–80 % (при температуре до 31 °C)